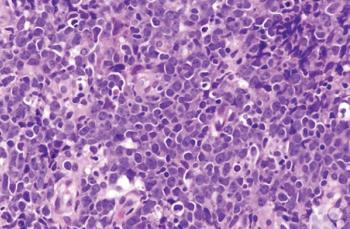

Test your diagnostic knowledge with this month's Image IQ.

Your AI-Trained Oncology Knowledge Connection!

Test your diagnostic knowledge with this month's Image IQ.

Experts review the current landscape and potential use of neoadjuvant chemotherapy with additional novel agents for patients with localized TNBC.

Multiple abstracts released via the virtual platform for the Society of Gynecologic Oncology (SGO) 2020 Annual Meeting on Women’s Cancer show mounting evidence for PARP inhibitors as the standard of care in the frontline setting for patients with ovarian cancer.

Experts discuss the case of a 56-year-old white man who presents with multiple immune-related adverse events

The chairman of the Glickman Urological & Kidney Institute at the Cleveland Clinic provides commentary and an adjacent perspective to the Duke Cancer Institute report.

ONCOLOGY® recently sat down with David R. Gandara, MD, director of the thoracic oncology program and senior advisor to the director of the University of California (UC) Davis Comprehensive Cancer Center, to discuss the impact of the pandemic on the current management and treatment of patients with lung cancer, as well as the future of education and patient care in a post–COVID-19 world.

Experts from the Duke Cancer Institute outline their current approach to stratifying surgical management of patients with prostate cancer.

Editor in chief Julie M. Vose, MD, MBA discusses the difficulties of treating and caring for patients with cancer during the COVID-19 pandemic.
